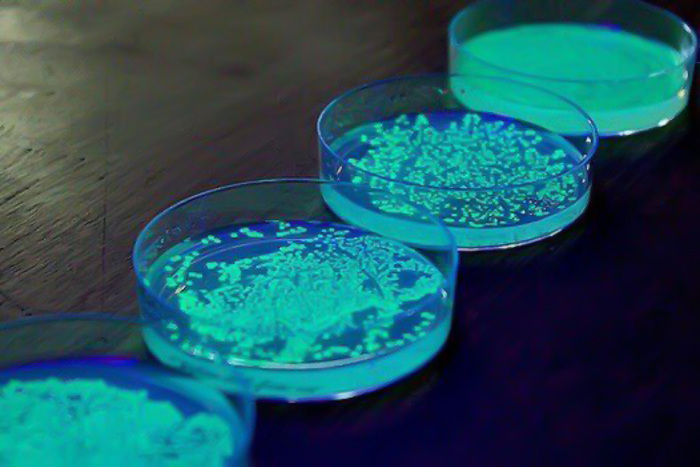
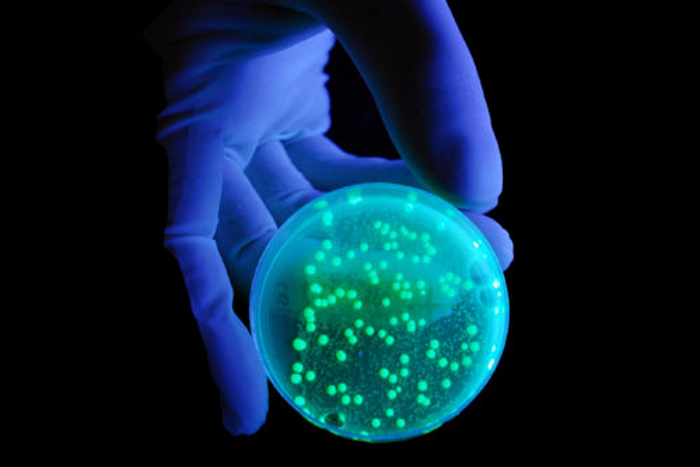

Необычная рыба, которую все знают, но не все представляют
Привет, мои дорогие любители необычной фауны планеты Земля. Сегодня у нас вкусная рубрика, и мы поговорим о рыбе, которая, я надеюсь, бывала на столе у каждого человека, живущего в нашей стране.
Итак, разрешите представить – палтус. Впрочем, словом "палтус" называют пять видов рыб, которые принадлежат разным родам. Поэтому уточним, что в данном очерке речь идёт об атлантическом белокором палтусе (Hippoglossus hippoglossus).
Многие из нас, конечно, знают как выглядит палтус – большие сочные куски белого мяса. Но, это не весь палтус, а лишь его богатый внутренний мир.
Вы спросите: "А чем, собственно, богат её внутренний мир?" В первую очередь жирными кислотами омега-3. Как вы знаете, эти соединения улучшают работу мозга, снижают риск сердечно-сосудистых заболеваний, помогают сохранить зрение, и даже являются профилактикой от болезни Паркинсона.
Кроме того, рыба богата жирами (около 5%) и белком (около 18%), но при этом довольно диетическая, и её энергетическая ценность не превышает 250 ККал на 100 граммов продукта.
Как можно догадаться по внешнему виду палтусы относятся к семейству камбаловых, и ведут придонный образ жизни. И, как и водится у камбал, имеют перекрученное тело.
То есть лежат они не на брюхе, а на боку, левый плавник у них на самом деле спинной, а правый – анальный.
По своей сути данный вид – хищник, нападающий из засады, так как плавает он посредственно. При этом его добычей становятся не только головоногие и ракообразные, которыми он питается в раннем возрасте, но и крупные виды рыб, вроде пикши и трески.
Распространена эта рыба довольно широко, от Бискайского залива на западе до Новой Земли на востоке, а на западном побережье Атлантики встречается от Канады до Нью-Йорка. Однако несмотря на широкое распространение, вид уже попал статус уязвимых из-за чрезмерного вылова.
Ну, а у меня всё. Надеюсь вас развлёк мой небольшой очерк. Он составлен по материалам моего телеграм-канала "Планетяне". Если вам интересно каждый день узнавать о необычной природе нашей планеты, приглашаю на борт: